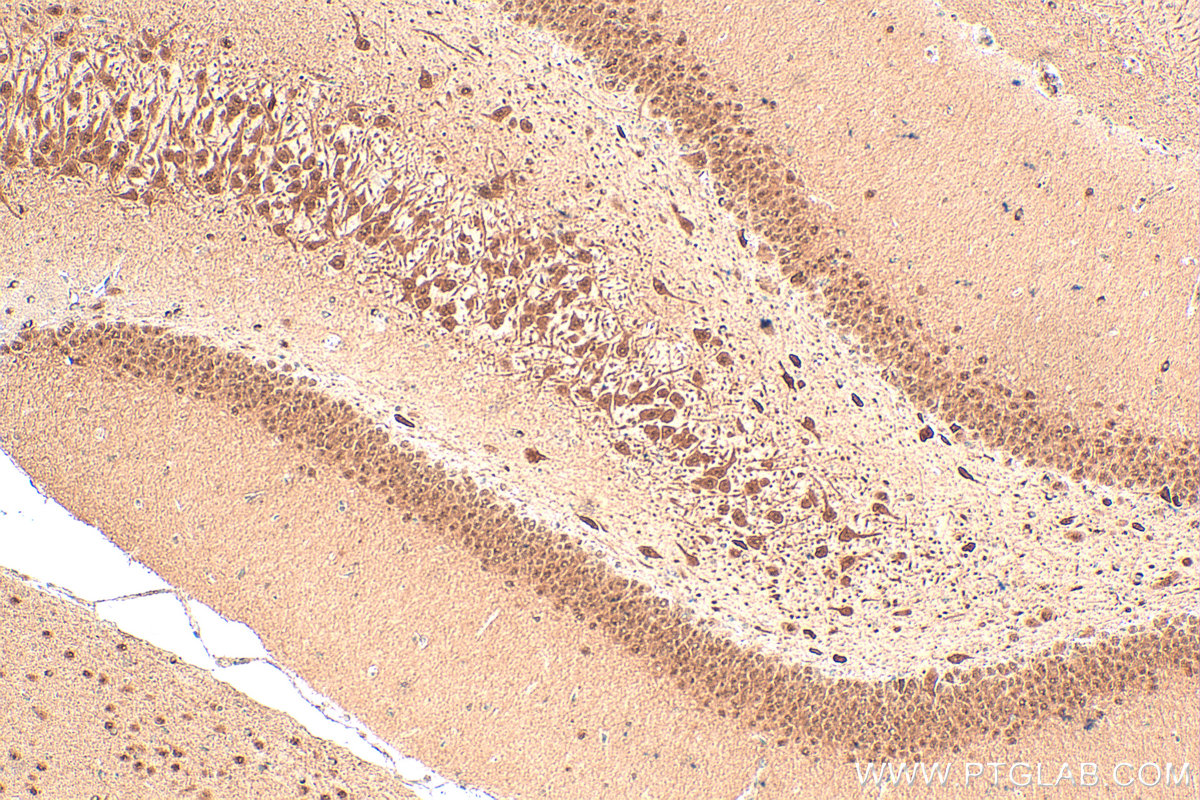
Immunohistochemical analysis of paraffin-embedded rat brain tissue slide using 12651-1-AP (SIAH2 antibody) at dilution of 1:100 (under 10x lens). Heat mediated antigen retrieval with Tris-EDTA buffer (pH 9.0). IHC staining of rat brain using 12651-1-AP

验证数据展示
经过测试的应用
| Positive WB detected in | MCF-7 cells, mouse brain tissue, MDA-MB-231 cells |
| Positive IP detected in | MCF-7 cells |
| Positive IHC detected in | rat brain tissue, mouse brain tissue Note: suggested antigen retrieval with TE buffer pH 9.0; (*) Alternatively, antigen retrieval may be performed with citrate buffer pH 6.0 |
| Positive IF/ICC detected in | PC-12 cells |
推荐稀释比
| 应用 | 推荐稀释比 |
|---|---|
| Western Blot (WB) | WB : 1:1000-1:4000 |
| Immunoprecipitation (IP) | IP : 0.5-4.0 ug for 1.0-3.0 mg of total protein lysate |
| Immunohistochemistry (IHC) | IHC : 1:50-1:500 |
| Immunofluorescence (IF)/ICC | IF/ICC : 1:50-1:500 |
| It is recommended that this reagent should be titrated in each testing system to obtain optimal results. | |
| Sample-dependent, Check data in validation data gallery. | |
产品信息
12651-1-AP targets SIAH2 in WB, IHC, IF/ICC, IP, ELISA applications and shows reactivity with human, mouse, rat samples.
| 经测试应用 | WB, IHC, IF/ICC, IP, ELISA Application Description |
| 文献引用应用 | WB, IHC, IF, IP |
| 经测试反应性 | human, mouse, rat |
| 文献引用反应性 | human, mouse, rat |
| 免疫原 |
CatNo: Ag3342 Product name: Recombinant human SIAH2 protein Source: e coli.-derived, PGEX-4T Tag: GST Domain: 1-324 aa of BC013082 Sequence: MSRPSSTGPSANKPCSKQPPPQPQHTPSPAAPPAAATISAAGPGSSAVPAAAAVISGPGGGGGAGPVSPQHHELTSLFECPVCFDYVLPPILQCQAGHLVCNQCRQKLSCCPTCRGALTPSIRNLAMEKVASAVLFPCKYATTGCSLTLHHTEKPEHEDICEYRPYSCPCPGASCKWQGSLEAVMSHLMHAHKSITTLQGEDIVFLATDINLPGAVDWVMMQSCFGHHFMLVLEKQEKYEGHQQFFAIVLLIGTRKQAENFAYRLELNGNRRRLTWEATPRSIHDGVAAAIMNSDCLVFDTAIAHLFADNGNLGINVTISTCCP 种属同源性预测 |
| 宿主/亚型 | Rabbit / IgG |
| 抗体类别 | Polyclonal |
| 产品类型 | Antibody |
| 全称 | seven in absentia homolog 2 (Drosophila) |
| 别名 | 5N16, E3 ubiquitin-protein ligase SIAH2, EC:2.3.2.27, hSiah2, RING-type E3 ubiquitin transferase SIAH2 |
| 计算分子量 | 324 aa, 35 kDa |
| 观测分子量 | 35-40 kDa |
| GenBank蛋白编号 | BC013082 |
| 基因名称 | SIAH2 |
| Gene ID (NCBI) | 6478 |
| RRID | AB_2877868 |
| 偶联类型 | Unconjugated |
| 形式 | Liquid |
| 纯化方式 | Antigen affinity purification |
| UNIPROT ID | O43255 |
| 储存缓冲液 | PBS with 0.02% sodium azide and 50% glycerol, pH 7.3. |
| 储存条件 | Store at -20°C. Stable for one year after shipment. Aliquoting is unnecessary for -20oC storage. |
背景介绍
The mammalian Seven-in-absentia homolog 2 (SIAH2), is a RING finger type ubiquitin ligase with a catalytic RING domain on its N-terminus, followed by two zinc fingers and a C-terminal substrate binding domain. Siah is a mammalian homolog of Sina, a Drosophila protein functioning in eye development. Mammals express two isoforms, Siah1 and 2, and mice exhibit two Siah1 isotypes, 1a and 1b. SIAH2 indirectly regulates the level of HIF-1α by promoting degradation of PHDs by UPS. SIAH2, in turn, is positively regulated by hypoxia-dependent transcriptional and posttranscriptional mechanisms.
实验方案
| Product Specific Protocols | |
|---|---|
| IF protocol for SIAH2 antibody 12651-1-AP | Download protocol |
| IHC protocol for SIAH2 antibody 12651-1-AP | Download protocol |
| IP protocol for SIAH2 antibody 12651-1-AP | Download protocol |
| WB protocol for SIAH2 antibody 12651-1-AP | Download protocol |
| Standard Protocols | |
|---|---|
| Click here to view our Standard Protocols |
发表文章
| Species | Application | Title |
|---|---|---|
Nat Cell Biol Heat stress activates YAP/TAZ to induce the heat shock transcriptome.
| ||
J Exp Clin Cancer Res PHB2 promotes SHIP2 ubiquitination via the E3 ligase NEDD4 to regulate AKT signaling in gastric cancer | ||
Int J Biol Sci Cold atmospheric plasma potentiates ferroptosis via EGFR(Y1068)-mediated dual axes on GPX4 among triple negative breast cancer cells | ||
Cell Death Dis PIWIL2 suppresses Siah2-mediated degradation of HDAC3 and facilitates CK2α-mediated HDAC3 phosphorylation. | ||
Int Immunopharmacol Methylene blue targets PHD3 expression in murine microglia to mitigate lipopolysaccharide-induced neuroinflammation and neurocognitive impairments |